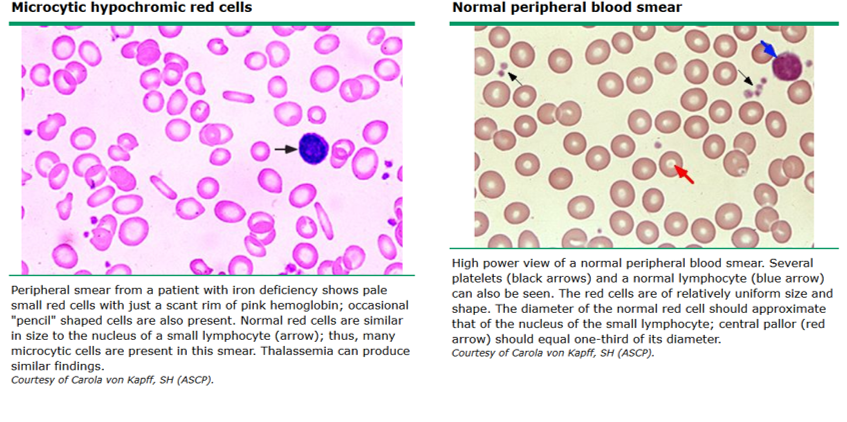

¿Cómo se define ANEMIA?
Disminución de la masa total de glóbulos rojos circulantes en el plasma, la cual resulta insuficiente para liberar la cantidad suficiente de oxígeno en los tejidos.
¿La anemia es una enfermedad?
NO, es la manifestación de un proceso, por lo que siempre debe ser investigado si no se tiene una causal.
“La principal consecuencia de la anemia ocurre a causa de la ________ ________”
hipoxia tisular
- De aquí se explican sus síntomas (fatiga, palidez, disnea…)
¿Cuáles son los mecanismos compensatorios de la anemia?
- Reducción de la afinidad por oxigeno de la hemoglobina
- Incremento del riego tisular (actividad vasomotora y angiogénesis)
- Aumento del gasto cardiaco (gen. Hgb <7g/dl)
- Aumento de la función pulmonar
- Aumento de la producción de eritrocitos (principalmente por aumento de la síntesis de EPO)
¿Cuáles son las 3 CAUSAS GENERALES de anemia?
1) Producción deficiente
2) Destrucción aumentada
3) Pérdida sanguínea
¿Bajo que valores de hemoglobina se considera anemia en hombre y mujer?
- Hombres <13 Hg
- Mujeres <12 Hg
Cuando el recuento de reticulocitos se encuentra incrementado (regenerativa) ¿En qué tipos de anemia debo pensar?
- Anemia por hemólisis (por destrucción)
- Anemia por hemorragia (pérdidas sanguíneas).

Cuando el recuento de reticulocitos se encuentra normal o disminuido ¿En qué tipos de anemia debo pensar?
- Anemia microcítica
- Anemia macrocítica
- Anemia normocítica

¿Cuáles son los 3 aspectos críticos que siempre hay que considerar?
- Historia clínica
- Hemograma completo / reticulocitos
- Frotis periférico
¿Cuál es la causa más frecuente de anemia a nivel mundial?
ANEMIA FERROPÉNICA
¿En qué consiste la anemia ferropénica?
Constituye la consecuencia final de la depleción de los depósitos de hierro en el cuerpo.
* Es de larga data (crónica)
¿Cuáles son las etiologías más frecuentes de la anemia ferropénica?
- Perdidas crónicas de sangre (Pérdidas menstruales, Pérdidas gastrointestinales)
- Bajo hierro en la dieta (principalmente vegetarianos/veganos)
- Malabsorción
¿Qué papel cumple la hepcidina en la absorción del Fe?
Es una hormona peptídica, producida en el hígado y considerada un regulador del metabolismo del hierro.
Aumenta en los cuadros inflamatorios, y cuando aumenta disminuye la absorción y utilización de Fe (es una sustancia de contrarregulación).

¿Los siguientes parámetros están disminuidos o aumentados en la anemia ferropénica?
* Fe sérico
* TIBC (capacidad total de fijación de Fe)
* Saturación de transferrina
* Ferritina
- Fe sérico –> disminuido
- TIBC –> aumentado
- Sat de transferrina –> disminuido
- ## Ferritina –> disminuidoOJO: la ferritina frente a un estado inflamatorio estará aumentada.

¿Cómo se observa al frotis una anemia ferropénica?
- Trombocitosis
- Microcitosis
- Hipocromia
Dentro de los principios del manejo en la anemia ferropénica encontramos:
1) Confirmar diagnostico
2) Identificar la causa
3) Corregir la causa
4) Aportar hierro oral o endovenoso
5) Confirmar respuesta
Respecto al paso 3 ¿Qué medidas se pueden adoptar según la causa?
- Medidas dietéticas (Alimentos altos en hierro: carnes, hígado, legumbres)
- Control de sangrado (Tratamiento de condición gastrointestinal, Uso de anticonceptivos en sangrados menstruales)
- Si no hay causa obvia –> DERIVAR
Dentro de los principios del manejo en la anemia ferropénica encontramos:
1) Confirmar diagnostico
2) Identificar la causa
3) Corregir la causa
4) Aportar hierro oral o endovenoso
5) Confirmar respuesta
Respecto al paso 4 ¿Cuáles son las indicaciones para la terapia de hierro oral?
- Sulfato ferroso (200mg) u otra presentación de hierro
- UNA VEZ AL DIA, 1 hora post comida, cada 48 hrs si solo hay ferropenia
- Mantener por 6 meses min.
- Se puede asociar a vitamina C.
- Evitar cafeína y alimentos cercano a comprimido
- Control a las 5-6 semanas.
Dentro de los principios del manejo en la anemia ferropénica encontramos:
1) Confirmar diagnostico
2) Identificar la causa
3) Corregir la causa
4) Aportar hierro oral o endovenoso
5) Confirmar respuesta
Respecto al paso 4 ¿Cuándo se debe indicar hierro parenteral/EV? ¿Cuáles son sus formas de administración?
- Mala tolerancia oral
- Refractariedad
- ERC
- Insuficiencia cardiaca
- EII
FORMAS ADMINISTRACION
* Hierro sucrosa (venofer)
- Dosis 100-200 mg EV por sesión para lograr 1000 mg en total
* Hierro carboximaltosa
- Dosis 500-1000 mg EV
OJO: estos casos se DERIVAN, la terapia se realiza en CAE.
¿Qué tipo de anemia se diferencia de la anemia ferropénica por tener ferritina elevada?
ANEMIA CRÓNICA/INFLAMACIÓN
* Inicialmente se presenta como normocítica, pero puede progresar a microcítica en casos prolongados
¿Cómo se explica la deficiencia de Fe en la anemia crónica/inflamación?
La anemia crónica/inflamación es causada principalmente por restricción de uso de hierro en la eritropoyesis (si hay Fe, solo que no se esta absorbiendo o usando).
* Se presume efecto beneficioso del hierro en patógenos
* IL6 aumenta producción de hepcidina
- Disminuye absorción de hierro intestinal
- Disminuye liberación de hierro de los macrófagos
¿Cuál es el manejo de la anemia crónica/inflamación?
- El manejo es de la patología de base
- Alternativas:
- Eritropoyetina
- Hierro EV en casos de ferritina <100
¿En qué consiste la anemia megaloblástica?
- Es un tipo de anemia macrocítica (VCM >100)
- Generalmente ocurre en condiciones en la que la síntesis de ADN y del núcleo esta limitada –> déficit de B12 o ácido fólico
- Pueden cursar con otras citopenias y neutrófilos hipersegmentados
- Pueden tener signos de hemólisis (BLR indirecta alta y LDH elevado
¿Cuál es la principal etiología de la anemia megaloblástica por déficit de B12?
Déficit de factor intrínseco (anemia perniciosa)* –> el factor hace que se absorba la vitamina B12 en el duodeno.
OTRAS: Vegetarianos estrictos, Gastrectomia, Teniasis
¿Qué síntomas puede producir la anemia megaloblástica por déficit de B12?
Déficit prolongados pueden cursar con síntomas neurológicos por degeneracion de cordones posteriores (alteración motor fino, ataxia, convulsiones, etc).
OJO: La Cianocobalamina esta presente en depósitos que duran varios meses en el cuerpo.



